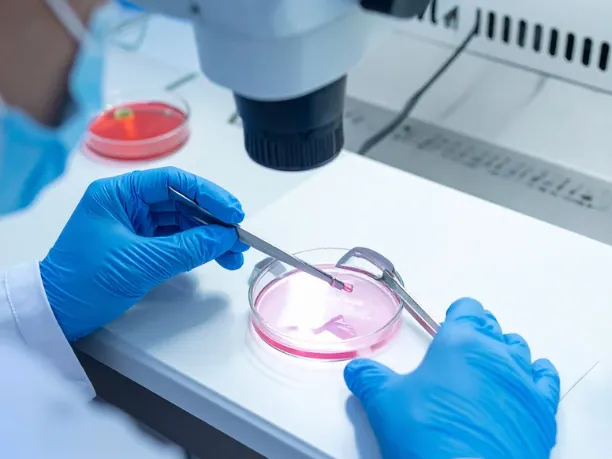
“有利な変異”の中には、実は「機能を失う変異」も

【専門家が解説】高齢出産リスクは母だけではない―“父親年齢リスク”のメカニズム
2025.10.29

新型出生前診断(NIPT)の普及により、女性の年齢とダウン症などの遺伝疾患のリスクが増えることは言われています。では父の年齢は関係ないでしょうか?出産時の父親の年齢も増加傾向にあるので、年齢による精子の変異率に関する研究を紹介します。
「父親の年齢が上がると、子どもに新しい遺伝子変異が増える」
これまで多くの研究で知られてきたこの事実に、新しい説明の手がかりが加わりました。2025年10月に科学誌 Nature に掲載された論文は、男性の精子の中で「有利な変異がクローンとして増える」現象――つまり陽的選択(positive selection)が、これまで考えられていたよりも広く起きていることを報告しました。
この発見は、遺伝子変異と父親年齢リスクの関係を見直す重要な研究です。
精子の中でも「変異」は増えるが、ゆっくり進む

研究チームは、24?75歳の男性57人から精液を採取し、最新の高精度シークエンス技術「NanoSeq」を使って精子DNAを詳細に解析しました。比較のために血液細胞のDNAも調べ、変異の蓄積スピードを比べています。
結果、精子のDNAでは1年に平均1.7個の変異が新たに生じることがわかりました。これは血液などの体細胞で起こる変異(年間約20個)よりもはるかに少なく、精子を作る細胞が非常に厳密に守られていることを示しています。
つまり、生殖細胞系統は体細胞よりも変異が「ゆっくり進む」特別な環境にあるのです。
しかし「ゆっくり」でも、“選ばれる変異”がある

ここからが今回の研究の核心です。
解析の結果、精子のDNAでは中立的な変異(偶然に起こるだけの変化)だけでなく、特定の遺伝子変異が優先的に増えていく「陽的選択」の兆候が見つかりました。
全ゲノムの中で非同義置換(たんぱく質を変える変異)と沈黙変異(影響のない変異)の比を調べると、通常は1に近いはずの比率が1.07に上昇していました。
このわずかな差が意味するのは、「精子を作る幹細胞の中で、有利な変異を持つ細胞が少しずつ勢力を伸ばしている」ということです。
“有利な変異”の中には、実は「機能を失う変異」も
興味深いのは、この“有利な変異”の多くが機能を失うタイプの変異(loss-of-function変異)だったことです。
これまで、陽的選択を受けるのは「機能が強まる変異(gain-of-function)」と考えられてきましたが、今回の結果ではむしろ逆。
研究では40の遺伝子が選択を受けており、そのうち約30遺伝子では「たんぱく質の働きを弱める変異」がクローンとして拡大していました。
これらの遺伝子の多くは、RAS-MAPKやWNT、TGFβなどのシグナル伝達経路、あるいはエピジェネティクスやRNA代謝に関係しています。
つまり、精子形成を支える細胞の中では、「細胞の自己増殖を助ける変異」が結果的に優位になる構造があると考えられます。
父親の年齢が上がると、リスクを持つ精子も増える

研究チームは、年齢別に精子1個あたりの変異率を推定しました。
その結果、30代では約2%の精子が「疾患に関係する可能性のある変異」を持つのに対し、70代ではその割合が約4.5%に上昇していました。
つまり、年齢を重ねるにつれて、“陽的選択を受けた精子”が増えていくという傾向が見えてきたのです。
これは、従来知られていた「年齢とともに単純に変異が増える」というだけでなく、変異の中身にも偏りが生じるという新しいリスク要因を示唆します。
結果的に、父親の年齢が高いほど、子どもに伝わる可能性のある疾患関連変異が増える――これが今回の研究が明確にした点です。
なぜこれは重要なのか?
この発見は、遺伝学・生殖医学の両方にとって大きな意味を持ちます。
まず、男性生殖細胞の中で選択が起きているというのは、これまで一部の遺伝子でしか確認されていませんでした。今回の研究は、数十の遺伝子にその現象が広がっていることを初めて示しました。
さらに、精子形成の過程で「機能喪失変異」が選ばれるというのは予想外の結果です。
このことは、進化生物学の観点からも重要で、“有利”とは必ずしも生命全体に良い意味ではなく、生殖細胞にとって都合が良いだけという可能性を示唆しています。
一方で、そのような変異が子どもに受け継がれると、発達障害やがんなどの疾患リスクにつながることも考えられます。
\お腹の赤ちゃんの遺伝性疾患リスクがわかる/
高齢父親のリスクをどう考えるか

この研究結果を踏まえると、父親年齢が高くなることで生じるリスクは単に「変異数が増える」だけではなく、変異の選ばれ方が変わる点に注目する必要があります。
もちろん、多くの精子は正常であり、ほとんどの子どもは健康に生まれます。しかし、確率的に見ると、加齢によって“疾患関連の変異をもつ精子”の割合が増えるという事実は無視できません。
今後、遺伝カウンセリングや生殖医療の分野では、こうした「生殖細胞内でのクローン選択」を考慮した説明や検査の在り方が求められていくかもしれません。
遺伝子検査ができること

私たちのような遺伝子検査機関では、最新のゲノム解析技術を活用し、変異の検出だけでなく、どのようなメカニズムでそれが生じるのかを理解することにも力を入れています。
今回の研究は、加齢による変異蓄積や父親年齢リスクを、より精密に評価する新しい方向性を示しました。
将来的には、生殖細胞の遺伝子変化を解析することで、次世代のリスク評価や生殖医療の個別化につながる可能性があります。
まとめ
- 精子では体細胞よりも変異がゆっくり蓄積するが、「陽的選択」により特定の変異が増える。
- その多くは機能喪失型の変異であり、精子形成に有利だが子に伝わると疾患リスクとなる可能性がある。
- 父親年齢が高くなると、そのような変異を持つ精子の割合は約2倍に上昇。
- この知見は、遺伝カウンセリングや検査、さらには進化の理解にも新たな視点をもたらす。
\お腹の赤ちゃんの遺伝性疾患リスクがわかる/
【参考文献】
Gao, J. et al. Sperm sequencing reveals extensive positive selection in the male germline. Nature (2025).seeDNA遺伝医療研究所の安心サポート
seeDNA遺伝医療研究所は、国際品質規格ISO9001とプライバシー保護のPマークを取得している安心と信頼のDNA鑑定・遺伝子検査の専門機関です。
お腹の赤ちゃんの親子の血縁関係や疾患リスク、パートナーの浮気などにお悩みでしたら、遺伝子検査の専門家が、しっかりとご安心いただけるようサポートいたしますのでお気軽にお問合せください。
【専門スタッフによる無料相談】

 著者
著者
医学博士 富金 起範
筑波大学、生体統御・分子情報医学修士/博士課程卒業
2017年に国内初となる微量DNA解析技術(特許7121440)を用いた出生前DNA鑑定(特許7331325)を開発





